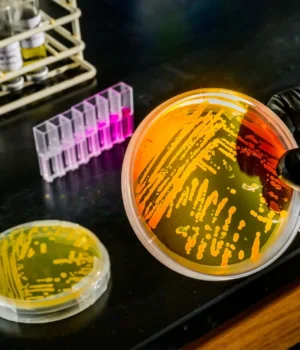

O aumento da temperatura dos oceanos, impulsionado pelas ondas de calor oceânicas e pelas alterações climáticas, está a atingir águas profundas, levantando preocupações sobre perturbações nos frágeis sistemas químicos e biológicos dos oceanos. Mas novas pesquisas sugerem que um micróbio marinho chave, Nitrosopumilus marítimoPode já ter se adaptado a condições mais quentes e mais pobres em nutrientes. Os cientistas acreditam que estes microrganismos adaptados, que dependem fortemente do ferro e conduzem à oxidação do amoníaco, podem afectar significativamente a forma como os nutrientes são distribuídos pelo oceano à medida que as mudanças climáticas.
Os resultados da pesquisa são exibidos Anais da Academia Nacional de Ciências.
Micróbios que alimentam o ciclo de nutrientes do oceano
Nitrosopumilus marítimo e micróbios intimamente relacionados constituem cerca de 30% do plâncton microbiano marinho. Muitos cientistas consideram-nos essenciais para a química marinha porque conduzem reações que sustentam os ecossistemas marinhos. Essas archaea oxidam a amônia, um processo que desempenha um papel central no ciclo do nitrogênio no oceano.
Ao converter o nitrogênio da água do mar em diferentes formas químicas, esses micróbios controlam o crescimento do plâncton microbiano. Estes minúsculos organismos formam a base da cadeia alimentar marinha, o que significa que a actividade das arquéias oxidantes do amoníaco ajuda, em última análise, a manter a biodiversidade oceânica.
O aquecimento das profundezas do oceano pode alterar a utilização do ferro
“Os efeitos do aquecimento dos oceanos podem estender-se a profundidades de 1.000 metros ou mais”, disse Wei Qin, professor de microbiologia da Universidade de Illinois Urbana-Champaign. “Costumávamos pensar que as águas profundas eram na sua maioria isoladas do aquecimento da superfície, mas agora está a tornar-se claro que o aquecimento dos oceanos profundos pode mudar a forma como estas arqueias abundantes utilizam o ferro – o metal de que mais dependem – afectando potencialmente a disponibilidade de vestígios de metais no oceano profundo.”
Experimentos mostram que micróbios usam o ferro com mais eficiência em águas mais quentes
A equipe de pesquisa, liderada por Keen e David Hutchins, professor de biologia de mudança global da Universidade do Sul da Califórnia, conduziu experimentos cuidadosamente controlados projetados para evitar vestígios de contaminação por metais. Eles estão abertos à cultura pura Nitrosopumilus marítimo Em diferentes temperaturas e em diferentes níveis de ferro.
Os seus resultados mostram que quando as temperaturas sobem sob condições de limitação de ferro, os micróbios precisam de menos ferro e utilizam-no de forma mais eficiente. Esta descoberta indica que os organismos podem ajustar o seu metabolismo para se adaptarem tanto às altas temperaturas como à redução da disponibilidade de ferro.
A modelagem sugere um papel futuro maior na química dos oceanos
“Combinamos essas descobertas com a modelagem biogeoquímica global dos oceanos feita por Alessandro Tagliabue, da Universidade de Liverpool”, disse Keane. “Os resultados sugerem que as comunidades de arqueas do fundo do mar podem manter ou aumentar o seu papel no apoio à ciclagem do azoto e à produção primária em grandes regiões limitadas por ferro num clima mais quente.”
Próximos resultados dos testes de expedição oceânica
No final deste verão, Keen e Hutchins atuarão como co-cientistas-chefes no navio de pesquisa Sikuliak. A expedição viajará de Seattle ao Golfo do Alasca e depois ao giro subtropical com parada em Honolulu, no Havaí.
A viagem incluirá 20 pesquisadores adicionais que examinarão as populações naturais de arqueas do oceano. O seu objetivo é confirmar resultados experimentais em condições do mundo real e compreender melhor como as mudanças de temperatura e a disponibilidade de metais interagem para moldar a atividade microbiana nas profundezas do mar.
Carl R. Kin para Biologia Genômica. Também associado ao Voice Institute.
A National Science Foundation, a Simmons Foundation, a National Natural Science Foundation of China, a University of Illinois Urbana-Champaign e a University of Oklahoma apoiaram esta pesquisa.